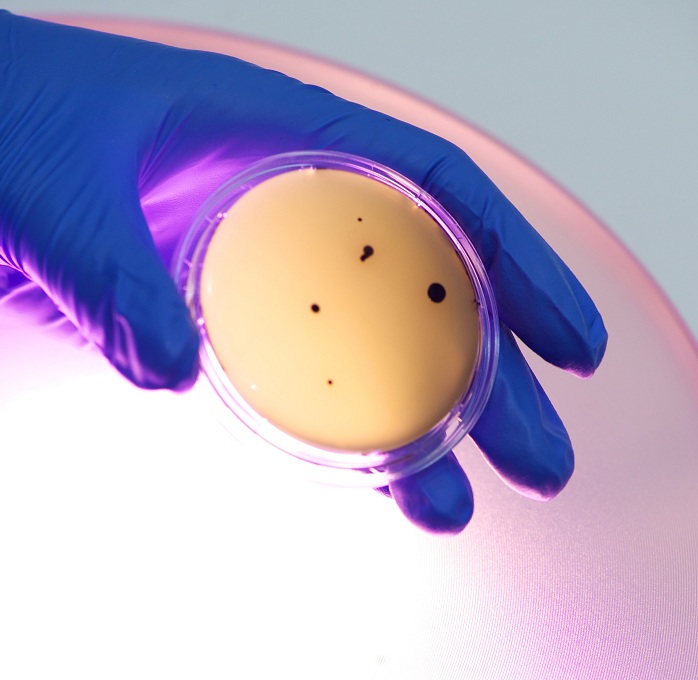

Contaminación microbiana en una placa de agar con una fuente de luz de potencia 405nm al fondo. Fuente: AlphaGalileo.
Hace cinco años, científicos de la Universidad Strathclyde de Glasgow, Escocia, anunciaban el desarrollo de un sistema lumínico pionero capaz de acabar con las bacterias hospitalarias más resistentes, como el Staphylococcus aureus resistente a meticilina (SARM) o la Clostridium difficile .
El sistema descontaminaba el aire y las superficies expuestas a bacterias, bañándolas con un espectro de luz visible conocido como luz-HINS (de High Intensity Narrow Spectrum Light), que acaba con los patógenos.
Desde la creación del sistema, se hicieron numerosas pruebas con él en el hospital Glasgow Royal Infirmary. Así se demostró que la técnica permitía reducir la presencia de patógenos de manera mucho más eficiente que los desinfectantes o la limpieza.
En algunos casos, con ella se logró eliminar hasta el 91% de los patógenos presentes en el lugar. La tecnología y su eficacia han sido, además, objeto de más de 20 publicaciones académicas arbitradas y de 30 presentaciones públicas.
Se venderá en EEUU y Canadá
Ahora, una empresa estadounidense llamada Kenall Manufacturing va a comercializar esta tecnología en EEUU y Canadá, en forma de Indigo-Clean ™, un dispositivo de iluminación o lámpara para la desinfección ambiental.
Indigo-Clean puede matar a las bacterias presentes en el aire o en cualquier superficie; y cumple con todas las normas internacionalmente reconocidas para la seguridad del paciente, es decir, que no daña al ser humano. Supondrá que, por vez primera, los hospitales puedan desinfectar de manera continua sus pabellones y habitaciones de aislamiento, por ejemplo.
Los creadores del sistema esperan que, por ello, sirva para evitar la frecuente expansión y proliferación de bacterias en los centros sanitarios y, en consecuencia, para reducir la posibilidad de enfermar durante los ingresos, por culpa de dichas bacterias.
El sistema descontaminaba el aire y las superficies expuestas a bacterias, bañándolas con un espectro de luz visible conocido como luz-HINS (de High Intensity Narrow Spectrum Light), que acaba con los patógenos.
Desde la creación del sistema, se hicieron numerosas pruebas con él en el hospital Glasgow Royal Infirmary. Así se demostró que la técnica permitía reducir la presencia de patógenos de manera mucho más eficiente que los desinfectantes o la limpieza.
En algunos casos, con ella se logró eliminar hasta el 91% de los patógenos presentes en el lugar. La tecnología y su eficacia han sido, además, objeto de más de 20 publicaciones académicas arbitradas y de 30 presentaciones públicas.
Se venderá en EEUU y Canadá
Ahora, una empresa estadounidense llamada Kenall Manufacturing va a comercializar esta tecnología en EEUU y Canadá, en forma de Indigo-Clean ™, un dispositivo de iluminación o lámpara para la desinfección ambiental.
Indigo-Clean puede matar a las bacterias presentes en el aire o en cualquier superficie; y cumple con todas las normas internacionalmente reconocidas para la seguridad del paciente, es decir, que no daña al ser humano. Supondrá que, por vez primera, los hospitales puedan desinfectar de manera continua sus pabellones y habitaciones de aislamiento, por ejemplo.
Los creadores del sistema esperan que, por ello, sirva para evitar la frecuente expansión y proliferación de bacterias en los centros sanitarios y, en consecuencia, para reducir la posibilidad de enfermar durante los ingresos, por culpa de dichas bacterias.
Cómo funciona
El sistema “HINS-ligth Environmental Decontamination” de Indigo-Clean funciona con un espectro de longitudes de onda en el rango de la luz visible, y en una potencia de 405 nanómetros (nm), informa la Universidad de Strathclyde en un comunicado difundido por AlphaGalileo.
Cuando dicho rango de luz es absorbido por las bacterias, excita las moléculas intracelulares presentes en éstas.
Esta excitación, a su vez, induce la producción de especies reactivas de oxígeno (iones de oxígeno, radicales libres y peróxidos tanto inorgánicos como orgánicos) que resultan letales para los agentes patógenos más resistentes. Así es como Indigo-Clean acaba con las bacterias desde el interior.
La luz llega a todas partes
Es sabido que en hospitales y centros clínicos se necesitan urgentemente nuevos métodos de desinfección y esterilización, dado que los métodos tradicionales presentan limitaciones significativas, explicaban en 2010 los autores del avance.
La razón de esta necesidad es que los métodos de descontaminación con gases esterilizantes o con radiación ultravioleta pueden resultar peligrosos para el personal hospitalario y para los pacientes.
Por otra parte, la limpieza, la desinfección y el lavado de manos, aunque son procedimientos rutinarios esenciales, presentan una efectividad limitada, así como problemas de cumplimiento riguroso.
En contraposición, la luz-HINS resulta un método seguro que puede automatizarse fácilmente, para que proporcione un estado de desinfección continua.
Asimismo, la penetrante naturaleza de la luz permite que la desinfección lumínica llegue a cualquier rincón del aire y a todas las superficies visibles, independientemente de su accesibilidad.
El sistema “HINS-ligth Environmental Decontamination” de Indigo-Clean funciona con un espectro de longitudes de onda en el rango de la luz visible, y en una potencia de 405 nanómetros (nm), informa la Universidad de Strathclyde en un comunicado difundido por AlphaGalileo.
Cuando dicho rango de luz es absorbido por las bacterias, excita las moléculas intracelulares presentes en éstas.
Esta excitación, a su vez, induce la producción de especies reactivas de oxígeno (iones de oxígeno, radicales libres y peróxidos tanto inorgánicos como orgánicos) que resultan letales para los agentes patógenos más resistentes. Así es como Indigo-Clean acaba con las bacterias desde el interior.
La luz llega a todas partes
Es sabido que en hospitales y centros clínicos se necesitan urgentemente nuevos métodos de desinfección y esterilización, dado que los métodos tradicionales presentan limitaciones significativas, explicaban en 2010 los autores del avance.
La razón de esta necesidad es que los métodos de descontaminación con gases esterilizantes o con radiación ultravioleta pueden resultar peligrosos para el personal hospitalario y para los pacientes.
Por otra parte, la limpieza, la desinfección y el lavado de manos, aunque son procedimientos rutinarios esenciales, presentan una efectividad limitada, así como problemas de cumplimiento riguroso.
En contraposición, la luz-HINS resulta un método seguro que puede automatizarse fácilmente, para que proporcione un estado de desinfección continua.
Asimismo, la penetrante naturaleza de la luz permite que la desinfección lumínica llegue a cualquier rincón del aire y a todas las superficies visibles, independientemente de su accesibilidad.

 Tendencias Científicas
Tendencias Científicas

La Inteligencia Artificial puede ver a través del espejo
La Inteligencia Artificial puede ver a través del espejo CIENCIA ON LINE
CIENCIA ON LINE